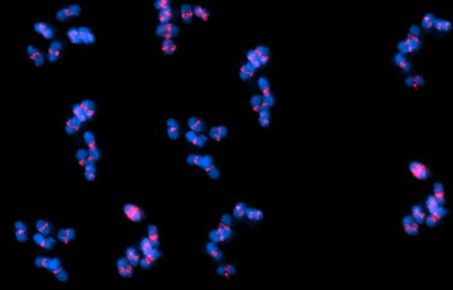

MRC Laboratory of Medical Sciences
MRC Laboratory of Medical Sciences
The MRC Laboratory of Medical Sciences (LMS) is a thriving biomedical research environment located within the heart of Hammersmith Hospital in partnership with Imperial College at its White City campus. The LMS forms a key component of the College's Institute of Clinical Sciences, and is a core-funded institute of the Medical Research Council.
Our scientific programmes are focused on three sections: Epigenetics, Genes and Metabolism, and Quantitative Biology. We also train and mentor the next generation of clinical and non-clinical scientists and strive to enhance the public’s interest, understanding and trust in science.